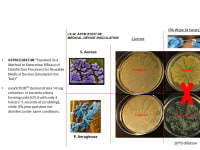

With a surge of COVID-19 patients flooding intensive care units (ICUs) nationwide, proper disinfection and maintenance of central venous catheters (CVC) and peripherally inserted central catheters (PICC) is more essential than ever to prevent complications, such as central line associated blood stream infections (CLABSI), from disrupting patient care and recovery.
In traditional years, there are 250,000 - 500,000 CLABSI cases reported in the USA, with ~80,000 of those occurring in ICUs. A hospital acquired CLABSI occurrence typically increases the patient stay by 7-25 days, with a mortality rate of 10-40%. , COVID-19 ICU patients are particularly susceptible to CLABSI mortality, as these critically ill patients often require hundreds of central line accesses per day for repeated administration of a variety of medicines and blood products. A simple and effective solution is needed to reduce CVC/PICC infection-related complications in COVID-19 and patients.
Hub Hygiene, Inc. is an Atlanta-based medical product manufacturer spun out from Georgia Tech in 2017 and now financially backed by BASF and Children’s National to develop easySCRUB, a patented (US# 10,166,085) and award-winning microreticulated polymeric foam technology for medical applications. We are currently undergoing Category I medical device packaging, sterility and biocompatibility testing with expected FDA clearance for human use by Q4/2020.
Each easySCRUB consists of an individually packaged, single-use, 2x2x1cm sugar cube-sized, open-cell microabrasive melamine foam sponge that is saturated with 0.4mL isopropyl alcohol (IPA). It is used in a scrubbing/twisting motion to promote and maintain cleanliness and sterility of the intravenous (IV) catheter hubs, ports, luer locks, septum and/or add-on device during connection and maintenance events. The easySCRUB technology is suitable within multiple infection-prone areas of a hospital system, including: ICUs, dialysis, oncology, emergency room (ER), pediatric, neonatal, maternity, and anesthesiology – among others.
Hub Hygiene Inc. has demonstrated through ASTM-E1837-96 “Standard Test Method to Determine Efficacy of Disinfection Processes for Reusable Medical Devices (Simulated Use Test)” conditions that our universally applicable easySCRUB microabrasive sponge material will rapidly and effectively remove and absorb CLABSI-causing bacteria (e.g., Staphylococcus aureus & Pseudomonas aeruginosa) during CVC/PICC-maintenance events without damage to the IV catheter, hub, septum, luer lock and/or add-on medical device being cleaned, even with exceptionally poor ‘scrub the hub’ protocol adherence.
Beyond its vastly superior cleaning efficacy as compared to traditional IPA-saturated prep pads, the easySCRUB technology also facilitates infection-control compliance and monitoring by emanating an audible ‘squeak’ when used as indicated, thereby reassuring the caregiver, patient and their loved ones of proper IV maintenance.
-
Awards
-
 2020 Top 100 Entries
2020 Top 100 Entries
Like this entry?
-
About the Entrant
- Name:Jud Ready
- Type of entry:individual
- Patent status:patented